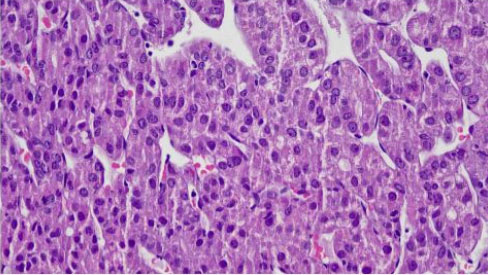

|
Case Series
Extrahepatic metastasis of hepatocellular carcinoma: A Malaysian case series
1 Medical Officer, Surgery, Melaka General Hospital, Melaka, Malaysia
2 Hepatobiliary Surgeon, Hepatobiliary Surgery, Melaka General Hospital, Melaka, Malaysia
3 Consultant Surgeon, General Surgery, Surgery, Melaka General Hospital, Melaka, Malaysia
Address correspondence to:
Ming Rhee Chai
81, Jalan Mawar, Taman Tan Leng Ann, 85000 Segamat, Johor,
Malaysia
Message to Corresponding Author
Article ID: 100099Z04MC2022
Access full text article on other devices

Access PDF of article on other devices

How to cite this article
Chai MR, Sankaran P, Yap LM. Extrahepatic metastasis of hepatocellular carcinoma: A Malaysian case series. Int J Hepatobiliary Pancreat Dis 2022;12(2):1–4.ABSTRACT
Introduction: Hepatocellular carcinoma (HCC) is a primary malignancy which arises from hepatocytes. It is the sixth most commonly diagnosed cancer and the third leading cause of cancer death worldwide in 2020. It predominantly metastasizes via the hematogenous route. However, there are possibility of distant metastasis via the lymphatic and bone dissemination in a few of HCC cases.
Case Series: We report two atypical cases of HCC with distant metastasis to cervical lymph node and bone in Malaysia. The first case reported is a HCC case of extrahepatic metastasis to cervical lymph node and the second case is a HCC case of extrahepatic metastasis to right femur.
Conclusion: The patients with atypical site of distant metastasis from HCC have poor prognosis. Overall physical examination should be done to prevent overlook for all the patients with HCC.
Keywords: Bone metastasis, Cervical lymph node metastasis, Extrahepatic metastasis, Hepatocellular carcinoma
Introduction
Hepatocellular carcinoma (HCC) is a primary malignancy which arises from hepatocytes. It arises predominantly from a precursor condition including chronic liver disease or liver cirrhosis liver around 75–85% of cases. Primary liver cancer is the sixth most commonly diagnosed cancer and the third leading cause of cancer death worldwide in 2020 [1]. Hepatocellular carcinoma is the fifth most common cancer in men and the ninth in women worldwide. In Malaysia it is the eighth most common cancer for both genders and fifth most common cause of cancer in males [2]. Metastasis occurs via three main routes: direct invasion, bloodstream, or lymphatic dissemination [3]. Common sites of systemic metastasis are to the lungs, abdominal lymph nodes, adrenal glands, or bones [4]. Diagnosis can be made using multiphase liver computed tomography (CT) or gadoxetate disodium magnetic resonance imaging (MRI) scans. In a small proportion of cases, a liver biopsy may be needed to establish the diagnosis [5]. Here, we report two atypical cases of HCC with metastasis to cervical lymph node and bone.
CASE SERIES
Case 1
A 64-year-old Chinese man was referred to our center for elevated alpha-fetoprotein (AFP) picked up during a health screening. He was previously an intravenous drug abuser and was recently diagnosed with Hepatitis C (Child Pugh A). Physical examination revealed a large left supraclavicular lymph node around measuring 4×4 cm and multiple spider nevi at his anterior chest. Abdominal examination was unremarkable.
Laboratory investigations revealed AFP 715 ng/mL, CA 19-9 3.46 U/mL, carcinoembryonic antigen (CEA) 7 ng/mL, total bilirubin 7.9 umol/L, Alanine transaminase (ALT) 32 U/L, Alkaline phosphate (ALP) 131 U/L, and Aspartate transaminase (AST) 80 U/L.
An ultrasound of abdomen revealed two ill-defined hypoechoic lesions in segment VI and V with common bile duct dilatation measuring 1.3 cm. There are a few enlarged lymph nodes seen in preaortic, aortocaval and periportal region, largest node noted at preaortic measuring 4.72.6 cm.
Computed tomography liver 4 phases showed multicentric hepatocellular carcinoma at segment V, VII, and VIII. The largest in segment VII measuring 2.2×2.5×1.9 cm. There are portal hepatic and abdominal lymph nodes metastasis causing intrahepatic biliary dilatation. The largest node is at aortocaval measuring 3.9×4.9×5.4 cm.
Excision biopsy of left cervical node was done, histology showed lymph node tissue fully replaced by infiltrating malignant tumor cells. Immunohistochemical stains CK7 and CK19 were positive and CK20, HepPar1, CEA were negative, suggestive of metastatic liver carcinoma.
Family conference was done and family opted for palliative treatment in view of poor ECOG (Eastern Cooperative Oncology Group) performance status. The patient passed away the following month due to disease progression.
Case 2
A 68-year-old Malay male was diagnosed with non-hepatitis B/C HCC in segment V and VI. In view of tumor size of about 10 cm and evidence of inferior vena cava (IVC) thrombosis he was planned for transarterial chemoembolization (TACE) and anticaogulation. His initial AFP level was 2.0 IU/mL. He had successfully undergone 5 sessions of TACE starting September 2020, which showed marginal tumor response and regression/progression of disease as evidence of tumor size to 8 cm. His AFP levels were never raised. Before his 6th session he had noticed a painless swelling over his right thigh which was progressively increasing in size. He completed his 6th session of TACE and performed a repeat CT which showed larger right liver mass occupying segment IV, V, VI, and VIII measuring 10.3×9.9×12.3 cm as compared to 9.3×9.9 cm previously. The adjacent hepatic vessels and ducts were compressed causing bilateral intrahepatic duct dilatation. There was also a left adrenal lesion measuring 3.1×3.2×4.4 cm. No lung nodules were detected. An MRI of his right lower limb which revealed well circumscribed solid mass arising from right femur medial periosteum measuring 3.84.6×7.7 cm. It is homogeneously hypointense on T1-weighted, intermediate signal on T2-weighted/STIR, enhancing post-contrast, suggestive of bone metastasis.
After discussion with the oncologist, a percutaneous biopsy of the right thigh mass was performed in July 2021. The histopathology examination (HPE) from the right thigh mass shows metastatic hepatocellular carcinoma. The malignant cells are positive for hepatocyte stain (Figure 1 and Figure 2). CD34 shows sinusoidal staining pattern (Figure 3 and Figure 4). His AFP at this time was 2.9 ng/mL. He was started on sorafenib but withheld in less than a month due to side effects of vomiting and diarrhea. Soon after discontinuation of the sorafenib he developed obstructive jaundice. Endoscopic retrograde cholangiopancreatography (ERCP) and stenting was done as a palliative intervention. The patient deteriorated and died within a month.
Discussion
Most patients with HCC are asymptomatic in the early stage of the disease. In the later stages, patients may develop hepatic decompensation; hence, patients might have the symptoms of jaundice, confusion, bleeding tendencies, or ascites. Majority of patients with HCC present at advanced stage. About 30–50% of patients in advanced stages has extrahepatic metastases (EHM). Hepatocellular carcinoma predominantly spreads via the hematogenous route. The most common site of EHM is the lungs, followed by abdominal lymph nodes and bones. Other modes of dissemination include portal vein thrombosis and lymphatic spread [6]. Most patients in advanced stage die of liver failure due to the progression of intrahepatic lesions rather than EHM dissemination, thus proper management of intrahepatic lesions is the key for better outcomes [7].
Autopsy study by Kanda et al. have showed that the frequency of lymph node metastasis in HCC is 21% [3]. Lymph node metastasis is rare and distant lymph nodes are rarely involved [2]. Most lymph flows toward the hepatic hilum through the hepatoduodenal ligaments. In contrast, a small amount of flow communicates with the diaphragmatic and intrathoracic lymphatic system via the bilateral triangular ligaments [8]. The atypical metastasis to the cervical lymph nodes reported in the first case may be due to the latter pathway. In fact, it was reported that cervical lymph node metastasis is more frequent in patients with tumors in the right upper lobe [2], which is seen in the first case. There is no standard treatment for EHM of HCC. Lymphadenectomy, radiation therapy, and chemotherapy have been considered treatments for lymph node metastasis of HCC after hepatectomy [9]. However, Lee et al. described lymphadenectomy not only produced minimal benefits but increased the risk of postoperative complications [10]. To minimize radiation related complications, it should be reserved for patients with metastases related symptoms such as pain and only when patients have well-controlled intrahepatic HCC without concurrent distant metastasis to other organs [11]. In our patient, the cervical lymph node was solitary, however, the primary tumor was inoperable.
Fukutomi et al. reported a frequency of 13% for HCC bone metastases with most common sites being the vertebrae, pelvis followed by ribs [12]. Bone metastasis mainly disseminate through hematogenous spread. Hepatocellular carcinoma cancer cells could disseminate to the bone through the portal vein, vertebral venous plexuses route, as well as systemic circulation. Cancer cell dissemination via hematogenous route to the bone may then be related to the higher incidence of bone metastasis in HCC as reported in the second case. Bone metastasis more frequently presents with symptoms such as bone pain compared to metastasis to other organs. Thus, the goal of treatment for bone metastasis is pain relief. The treatment modalities to relief bone pain that have been reported to be effective include radiotherapy, radio-frequency ablation (RFA), percutaneous vertebroplasty and bisphosphonates [11]. Targeted therapy like sorafenib or chemotherapy may be options in advanced stage HCC. Sorafenib is one of the first line drug, which has been extensively used in metastatic and inoperable HCC case [13]. Likewise, the patient in second case with EHM and intrahepatic lesion was treated with sorafenib as both intrahepatic and extrahepatic lesions were not operable.
Conclusion
In summary, the patients with atypical distant metastasis from HCC have poor prognosis. Metastasis to cervical lymph node and bone are rarely observed in patients with HCC. All patients with HCC should be considered the possibility of distant metastasis accompanying HCC. Therefore, overall physical examination should be done tediously to prevent overlook of any atypical distant metastasis.
REFERENCES
1.
Sung H, Ferlay J, Siegel RL, et al. Global cancer statistics 2020: GLOBOCAN estimates of incidence and mortality worldwide for 36 cancers in 185 countries. CA Cancer J Clin 2021;71(3):209–49. [CrossRef]
[Pubmed]

2.
Raihan R, Azzeri A, Shabaruddin HF, Mohamed R. Hepatocellular carcinoma in Malaysia and its changing trend. Euroasian J Hepatogastroenterol 2018;8(1):54–6. [CrossRef]
[Pubmed]

3.
Becker AK, Tso DK, Harris AC, Malfair D, Chang SD. Extrahepatic metastases of hepatocellular carcinoma: A spectrum of imaging findings. Can Assoc Radiol J 2014;65(1):60–6. [CrossRef]
[Pubmed]

4.
Kanda M, Tateishi R, Yoshida H, et al. Extrahepatic metastasis of hepatocellular carcinoma: Incidence and risk factors. Liver Int 2008;28(9):1256–63. [CrossRef]
[Pubmed]

5.
Bialecki ES, Di Bisceglie AM. Diagnosis of hepatocellular carcinoma. HPB (Oxford) 2005;7(1):26–34. [CrossRef]
[Pubmed]

6.
7.
Uchino K, Tateishi R, Shiina S, et al. Hepatocellular carcinoma with extrahepatic metastasis: Clinical features and prognostic factors. Cancer 2011;117(19):4475–83. [CrossRef]
[Pubmed]

8.
Tanoue K, Kawasaki Y, Yamasaki Y, et al. Postoperative recurrence with right cervical lymph node metastasis in hepatocellular carcinoma: A case report. Surg Case Rep 2021;7(1):260. [CrossRef]
[Pubmed]

9.
Zhao Z, Maia J, Zhang X, Yan H, Chen X, Liu X. A case report on the right cervical lymph node metastasis of hepatocellular carcinoma. J Cancer Sci Ther 2018;10(11):329–31. [CrossRef]

10.
Lee CW, Chan KM, Tsai HI, et al. Hepatic resection for hepatocellular carcinoma in the octogenarian: Is it justified? Aging (Albany NY) 2019;11(5):1537–50. [CrossRef]
[Pubmed]

11.
Lee HS. Management of patients with hepatocellular carcinoma and extrahepatic metastasis. Dig Dis 2011;29(3):333–8. [CrossRef]
[Pubmed]

12.
Fukutomi M, Yokota M, Chuman H, et al. Increased incidence of bone metastases in hepatocellular carcinoma. Eur J Gastroenterol Hepatol 2001;13(9):1083–8. [CrossRef]
[Pubmed]

13.
Huang A, Yang XR, Chung WY, Dennison AR, Zhou J. Targeted therapy for hepatocellular carcinoma. Signal Transduct Target Ther 2020;5(1):146. [CrossRef]
[Pubmed]

SUPPORTING INFORMATION
Acknowledgments
We would like to thank Dr. Mahfida Mahat and Dr. Diyana, Anatomic Pathologists from Department of Pathology of Hospital Melaka for providing the laboratory images.
Author ContributionsMing Rhee Chai - Conception of the work, Design of the work, Acquisition of data, Analysis of data, Drafting the work, Revising the work critically for important intellectual content, Final approval of the version to be published, Agree to be accountable for all aspects of the work in ensuring that questions related to the accuracy or integrity of any part of the work are appropriately investigated and resolved.
Padmaan Sankaran - Conception of the work, Design of the work, Acquisition of data, Analysis of data, Drafting the work, Revising the work critically for important intellectual content, Final approval of the version to be published, Agree to be accountable for all aspects of the work in ensuring that questions related to the accuracy or integrity of any part of the work are appropriately investigated and resolved.
Lee Ming Yap - Conception of the work, Design of the work, Revising the work critically for important intellectual content, Final approval of the version to be published, Agree to be accountable for all aspects of the work in ensuring that questions related to the accuracy or integrity of any part of the work are appropriately investigated and resolved.
Guarantor of SubmissionThe corresponding author is the guarantor of submission.
Source of SupportNone
Consent StatementWritten informed consent was obtained from the patient for publication of this article.
Data AvailabilityAll relevant data are within the paper and its Supporting Information files.
Conflict of InterestAuthors declare no conflict of interest.
Copyright© 2022 Ming Rhee Chai et al. This article is distributed under the terms of Creative Commons Attribution License which permits unrestricted use, distribution and reproduction in any medium provided the original author(s) and original publisher are properly credited. Please see the copyright policy on the journal website for more information.